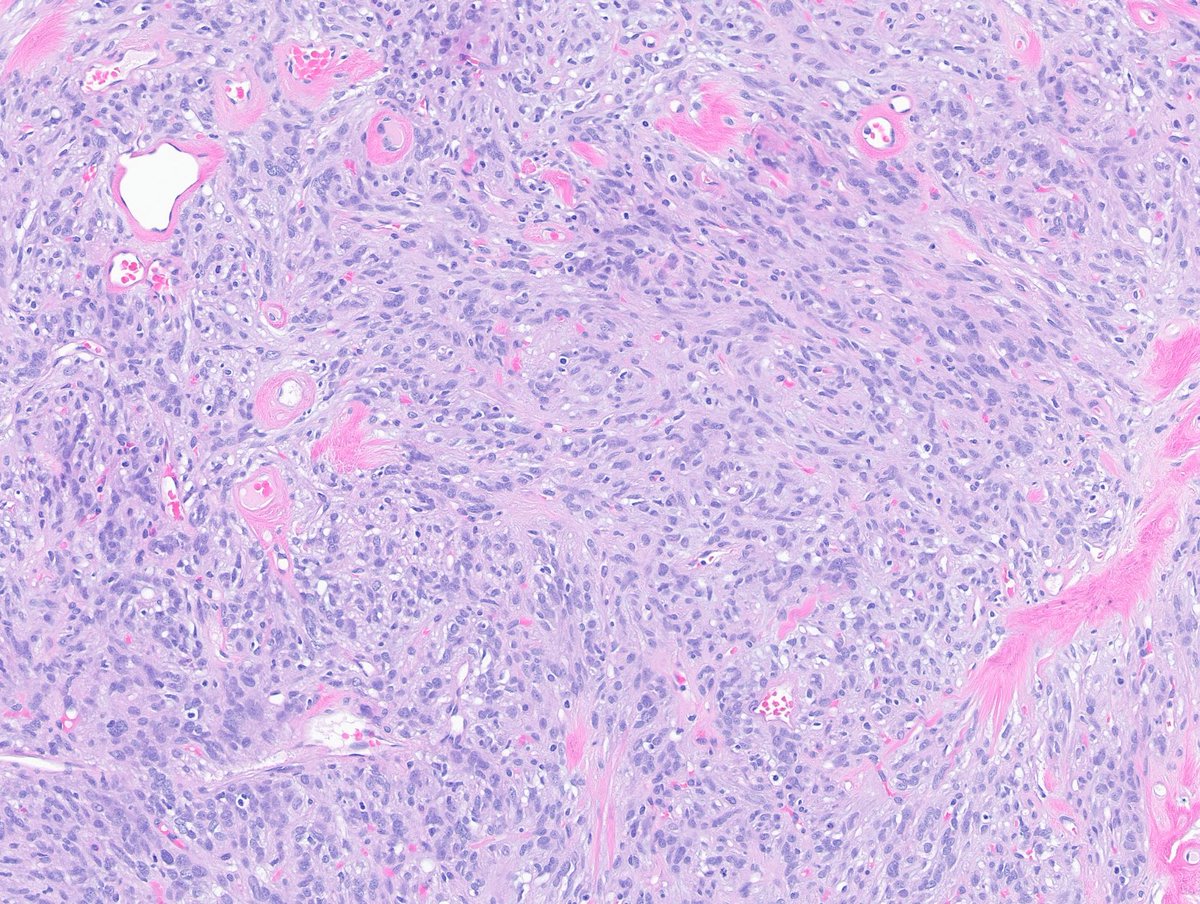
Greg_Charville's tweet image. A very vascular tumor indeed - however the neoplastic cells are not endothelial. Here's a better look at another part of the same tumor:
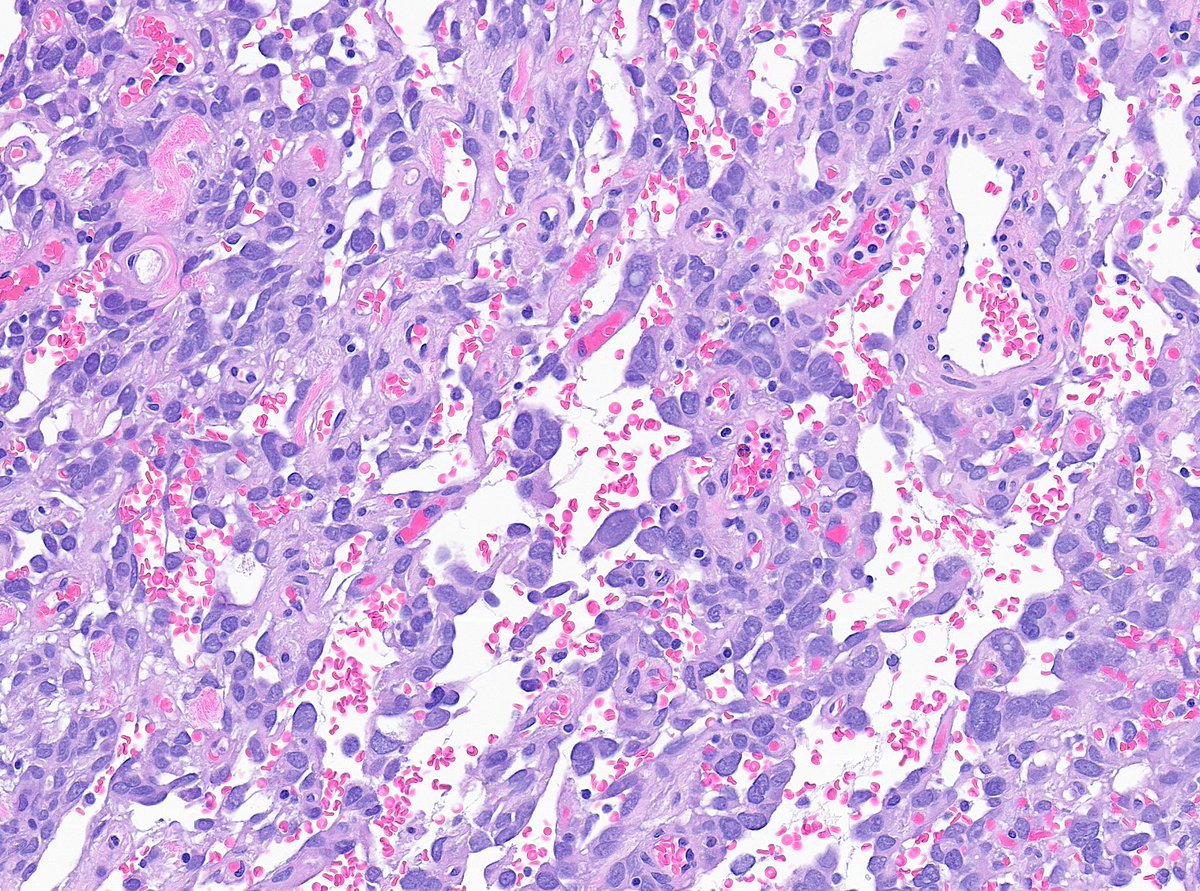
Greg_Charville's tweet image. What do you make of this tumor of the small bowel mesentery?🧐 #BSTpath #GIpath

Dr Gita Verma ,MD
@gitaharsh
Histopathologist ,speciality Onco ,at Nanavati Max . Happiness is family and the small things,interested in Indian history and temple architecture,art.
Anda mungkin suka
Landslide! 🙌 The breast sample shows bland storiform spindle cell neoplasm in dense fibrous stroma, studded with dilated ‘staghorn’ vasculature—findings of solitary fibrous tumor (SFT). SFT harbor NAB2::STAT6, caused by inversion of chr12. #PathX #PathTwitter #breastpath
What translocation is found in this tumor? 🧬🔬 Poll in comments below 👇 Answer revealed on Monday 🔮 #PathX #PathTwitter #breastpath #molpath

p53 IHC can help confirm a diagnosis of esophageal squamous dysplasia. In occasional HPV-associated cases, p16 staining is strongly reactive. This example is probably driven by a TP53 mutation. Don't expect the full thickness staining typical of glandular dysplasia.




IHC panel for basaloid tumors in salivary gland biopsies Dr. Nishino - 2025 Diagnostic Pathologic Update #USCAP #pathology #PathX

Elbow, 20y #pathology #patologia #pathoutpic #bstpath #dermpath




Not everything is what it seems. Middle-aged patient. Consult case. Minimal clinical data. Ileal resection for obstruction → tumor found. Let’s follow the diagnostic trail. Short thread, do the polls in order (and no sneak peek...)

#Prostate needle core biopsy. Diagnosis??? 🔬Intraductal carcinoma (IDC-P) 🔬Atypical intraductal prolif (AIP) 🔬Cribriform invasive carcinoma Answer in comment. #GrayZonePath 40 #GUPath


A very vascular tumor indeed - however the neoplastic cells are not endothelial. Here's a better look at another part of the same tumor:

Blood screens for medical pathology 💡

#DrBuiBSTCaseCollection 🌻Fat-rich Desmoid Fibromatosis. This case is CTNNB1-mutated, CD34 IHC-negative. A rare finding in a relatively common soft tissue tumor. Not a spindle cell lipoma. @PathX @Pathtwitter @USFpathology @MoffittNews @CAPA_comm


One of our brilliant residents showed me this case. Supraclavicular lymph node. No other clinical information at the moment. Micropapillary to papillary structures, some mitoses, some mucin production. (Short thread follows):

Breast Histologic Variants of Invasive Lobular Carcinoma (ILC) -Many of these variants coexists and could be difficult to separate one from the other New variants (WHO 6th edition) -ILC with extracellular mucin -ILC with solid papillary growth Dr. Sahin #USCAP25 #pathology…


Case of Ductal Carcinoma In-Situ (DCIS) 🍪🔬 ☑️ Neoplastic epithelial proliferation confined to ducts and lobules ☑️ May show variety of architectural patterns, like solid and cribriform 👇 ☑️ Graded by nuclear atypia #PathX #PathTwitter #breastpath

Awesome job! The answer was myofibroblastoma. ☑️ Bland spindle cells in collagenous stroma ☑️ Devoid of breast glands ☑️ Associated with monoallelic 13q14 loss IHC provided 👇. #PathX #PathTwitter #breastpath

What’s this spindle cell lesion of the breast? Poll in comments 👇 Answer revealed on Monday 🔮 #PathX #PathTwitter #breastpath

Histology of the lung explained by a pulmonary pathologist, part 1 youtu.be/Zm6lzuozJUc?si… via @YouTube

youtube.com
YouTube
Histology of the lung explained by a pulmonary pathologist, part 1
An open access guide to renal medullary carcinoma: journals.sagepub.com/doi/epub/10.32…

Histopathological featurs of CHRONICITY in colon biopsy #GIpath #PathX #Pathology

CC380. Two recent FNAs of large lymph nodes. Both are women with no relevant history A. Left, supraclavicular B. Right, axillary One is a lymphoma. Answer the test below. This nice paper by Elena Vigliar may be of help doi.org/10.1111/cyt.13… @DrBMcGinn

Adult male. Retroperitoneal mass. #PathX #PathTwitter #BSTPath




Thyroid neoplasms - Helpful IHC table Dr. Nishino - 2025 Diagnostic Pathology Update #USCAP #pathology #PathX

Prostate cancer: Gleason grading (Basic facts for residents)

United States Tren
- 1. Ash Wednesday N/A
- 2. Good Wednesday N/A
- 3. Hump Day N/A
- 4. Lent N/A
- 5. Hobi N/A
- 6. #wednesdaymotivation N/A
- 7. Deen N/A
- 8. Happy Hump N/A
- 9. #18Feb N/A
- 10. Mick Cronin N/A
- 11. Tom Noonan N/A
- 12. Ramadan N/A
- 13. $Punch N/A
- 14. Namjoon N/A
- 15. Tiki Ghosn N/A
- 16. Vini N/A
- 17. UCLA N/A
- 18. Landon N/A
- 19. June Carter N/A
- 20. Reform N/A
Anda mungkin suka
Something went wrong.
Something went wrong.













































































































